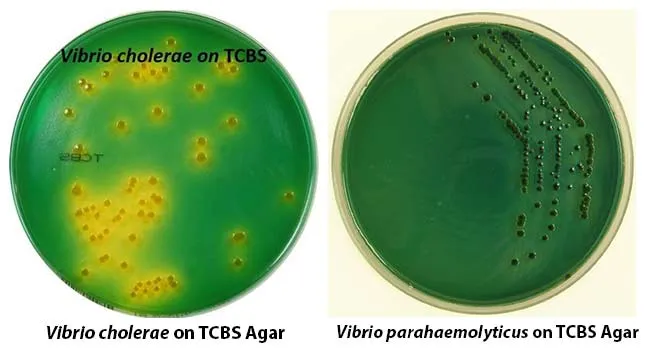
image

Aqua Rods - V.A.P. Intro
- General Features: Gram-negative rods, facultative anaerobes.
- Motility: Most are motile via polar flagella.
- Biochemical Test: Oxidase-positive.
- 📌 V.A.P. are Oxidase Positive: Very Awesome Pathogens.
- Natural Habitat: Predominantly aquatic environments (freshwater, brackish, marine).
- Clinically Important Genera: Vibrio, Aeromonas, Plesiomonas.
⭐ Most Vibrio, Aeromonas, and Plesiomonas species are oxidase-positive. This is a key biochemical test distinguishing them from the Enterobacteriaceae family, which are typically oxidase-negative.
Vibrio Spotlight - Cholera & Kin
- Vibrio cholerae:
- Serogroups: O1 (El Tor, Classical biotypes), O139 - cause cholera epidemics.
- Cholera Toxin (CT): A-B toxin. Mechanism: $G_s\alpha \xrightarrow{\text{ADP-ribosylation}} \text{activated } G_s\alpha \rightarrow \uparrow \text{adenylate cyclase} \rightarrow \uparrow cAMP \rightarrow \text{PKA activation} \rightarrow \text{CFTR phosphorylation} \rightarrow Cl^- \text{secretion}$. Leads to 'rice-water stool'.
- Lab: TCBS agar (sucrose fermenter $\rightarrow$ yellow colonies), oxidase (+), string test (+).
- Other Pathogenic Vibrios:
- V. parahaemolyticus: Common cause of seafood gastroenteritis. Kanagawa phenomenon (thermostable direct hemolysin, TDH). TCBS: green (sucrose non-fermenter).
- V. vulnificus: Severe wound infections, primary septicemia (raw oysters). High mortality. Lactose fermenter. TCBS: variable (often green, some strains ferment sucrose).
📌 Mnemonic - CHOLERA: Comma-shaped, Halophilic (most), Oxidase +, Lactose -, Epidemics, Rice-water stool, A-B toxin. 📌 TCBS: Yellow for Cholerae (Sucrose +), Green for paraHaemolyticus & Vulnificus (Sucrose Non-fermenters, mostly).
Pathogenesis of Cholera:
⭐ The El Tor biotype of Vibrio cholerae O1 produces acetoin (Voges-Proskauer test +), is more resistant to polymyxin B, causes a higher ratio of asymptomatic carriers to cases, and has longer environmental survival compared to the Classical biotype.
Aeromonas & Plesiomonas - The Other Water Warriors
- Aeromonas (📌 'A' for 'Against' O/129 - resistant)
- Species: A. hydrophila, A. caviae, A. veronii; often β-hemolytic.
- Diseases: Gastroenteritis, wound infections (contaminated water), septicemia (immunocompromised).
- Key: Resistant to O/129.
⭐ Aeromonas species are characteristically resistant to the vibriostatic compound O/129 (2,4-diamino-6,7-diisopropylpteridine), a key test to differentiate them from Vibrio and Plesiomonas species, both of which are generally susceptible.
- Plesiomonas (📌 'Pleases' by O/129 sensitivity; 'shares' shigelloides symptoms with Shigella but motile)
- Species: P. shigelloides.
- Diseases: Gastroenteritis (raw seafood/water), rare extraintestinal infections.
- Keys: Oxidase-positive (unlike Shigella), O/129 sensitive, ferments inositol.
Lab Detectives - Nailing the Diagnosis
Key lab tests differentiate Vibrio, Aeromonas, Plesiomonas (all GNR, Oxidase +):
| Test | Vibrio | Aeromonas | Plesiomonas |
|---|---|---|---|
| Gram Stain | GNR (curved) | GNR | GNR |
| Oxidase | + | + | + |
| Motility | + | + | + |
| MacConkey Growth | Yes (LF/NLF) | Yes (LF) | Yes (LF) |
| TCBS Growth | Yes (Y/G) | No/Poor | No/Poor |
| O/129 Sensitivity | S | R | S |
| String Test (V.c.) | + | - | - |
| 0% NaCl Growth | No (exc. V.c.) | Yes | Yes |
| Inositol Ferm. | - | - | + |
| LDC | Var (V.c.+) | - | + |
| ODC | Var (V.c.+) | Var | + |
| ADH | - | + | + |
⭐ The string test, where a mucoid string is formed when colonies of Vibrio cholerae are emulsified in 0.5% sodium deoxycholate solution, is a simple, rapid, and highly presumptive test for V. cholerae identification in resource-limited settings.
High‑Yield Points - ⚡ Biggest Takeaways
- Vibrio cholerae: Profuse rice-watery stools (cholera toxin ↑cAMP), TCBS agar (yellow colonies), string test positive.
- V. parahaemolyticus: Diarrhea from raw seafood; Kanagawa phenomenon (hemolysis).
- V. vulnificus: Severe wound infections, necrotizing fasciitis, septicemia in liver disease or immunocompromised.
- Aeromonas: Gastroenteritis, cellulitis/wound infections (aquatic exposure), oxidase-positive.
- Plesiomonas shigelloides: Gastroenteritis (watery/dysenteric), oxidase-positive, ferments inositol, shares antigens with Shigella.
- All are Gram-negative rods, motile, oxidase-positive, common in aquatic environments.
Unlock the full lesson and continue reading
Signup to continue reading this lesson and unlimited access questions, flashcards, AI notes, and more